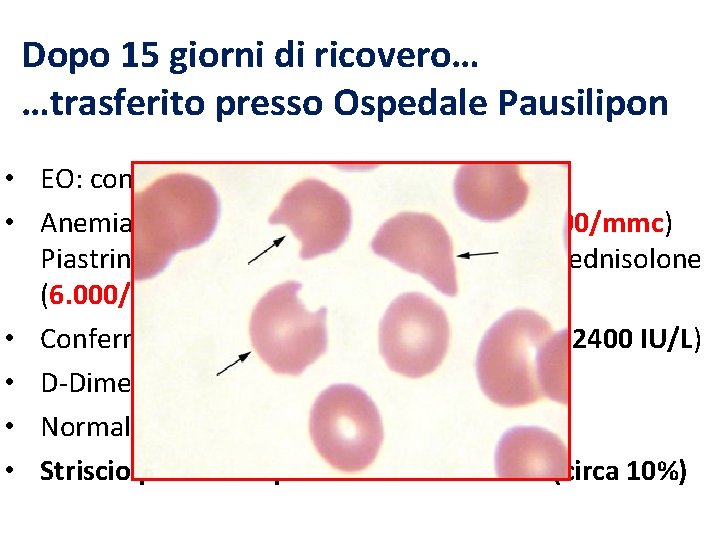
Dopo 15 giorni di ricovero… …trasferito presso Ospedale Pausilipon • EO: condizioni generali stazionarie

UNIVERSIT DEGLI STUDI DI NAPOLI FEDERICO II SCUOLA





























- Slides: 29

UNIVERSITÀ DEGLI STUDI DI NAPOLI “FEDERICO II” SCUOLA DI SPECIALIZZAZIONE IN PEDIATRIA Direttore: Prof. R. Troncone UNO STRANO CASO DI PIASTRINOPENIA Tutor Dott. G. Loffredo AIF Claudio Veropalumbo

Il caso di Giuseppe… Trasferito presso l’ospedale Pausilipon a 12 anni per: • Piastrinopenia (PLT 6000/mm 3) • Anemia (Hb 6. 7 g/dl) • Storia di ematuria

Anamnesi Familiare: Apparentemente non contributoria: Genitori non consanguinei Nessun problema di natura ematologica Anamnesi positiva per patologie autoimmuni: madre, zia materna e zia paterna affette da tiroidite autoimmune zia materna affetta da diabete mellito tipo I cugina con diagnosi di celiachia

Anamnesi Personale: Nessun problema clinico di rilievo fino a circa 7 gg prima del ricovero: Febbre (T max 39. 7°C) Alvo diarroico (3 scariche/die) Macroematuria (1 episodio) Ricovero presso altro nosocomio

Durante la degenza…. E. O. : • Condizioni generali mediocri. Peso 70 Kg, Altezza 170 cm. BMI 24. 22 (> 95°pc) • Attività cardiorespiratoria regolare. FC 100 bpm, FR 16 apm, PA 120/80 mm. Hg • Ecchimosi al tronco, petecchie diffuse arti inferiori e al cavo orale • Stazioni linfonodali esplorabili indenni • Organi ipocondriaci nei limiti

Durante la degenza…. Indagini laboratorio all’ingresso: • Hb 10. 6 g/dl, MCV 78 fl, • PLT 3. 000/mmc • WBC 6130/mmc, N 3. 900/mmc, L 1. 600/mmc • Reticolociti: 120. 000/mmc • Coombs negativo • AST, ALT: nella norma • Funzionalità renale ed esame urine: nella norma • LDH: 2943 IU/L (v. n. <500), BT: 3. 25 mg/dl (BI 2. 57 mg/dl) • PT 80%, a. PTT 28 sec, Fibrinogeno 400 mg/DL • D-Dimero 782 ng/ml (v. n. < 250)

Aspirato midollare iperplasia della serie megacariocitica. Non visti elementi atipici Sospetto PTI…. Infusione Ig e. v. : 0. 8 gr/Kg

Durante il ricovero… • Alvo regolare. Apiressia in II giornata. • PLT costantemente < 20. 000/mmc inizia metilprednisolone ev (100 mg/die poi aumentato a 150 mg/die) e II dose di Ig (0. 8 gr/Kg) dopo 10 gg • Progressiva anemizzazione con incremento reticolociti • DAT polispecifico: NEGATIVO (anche precortisone) • Anti DNA e ANA (pre. PDN): negativi

PDS g/dl Ig Ig
Dopo 15 giorni di ricovero… …trasferito presso Ospedale Pausilipon • EO: condizioni generali stazionarie • Anemia (Hb 6. 7 g/dl) e reticolocitosi (500000/mmc) Piastrinopenia resistente alle IVIG e metilprednisolone (6. 000/mmc) • Confermato aumento indici di emolisi (LDH 2400 IU/L) • D-Dimeri 255 ng/ml (v. n. < 250) • Normale funzionalità renale ed epatica • Striscio periferico: presenza di schistociti (circa 10%)

TROMBOCITOPENIA+ANEMIA Striscio Periferico + Coombs Senza schistociti Con schistociti Coombs neg. Coombs positivo SINDROMI MICROANGIOPATICHE CID SUE Coombs negativo PATOLOGIE IMMUNI S. di Evans TTP LES Kasabach-Merrit Cause minori: infezioni, vasculiti, ecc ALPS Ipo-aplasia midollare/Leucemia Anemia da perdita in PTI

Anemia e piastrinopenia con aumento indici di emolisi, schistociti e test di Coombs negativo IPOTESI DIAGNOSTICHE: - Citopenia da consumo CID

ISTH scoring system RISK ASSESSMENT: Condizioni sottostanti associate a CID? SI: procedi No: stop SCORE TEST COAGULATIVI: - Conta PLT (>100 x 109/l = 0; < 100 x 109/l = 1; < 50 x 109/l = 2) - Incremento markers fibrina (D-Dimero, FDP): (no incremento = 0, moderato = 1, marcato = 2) - Prolungato PT (<3 s = 0; >3 s ma < 6 s =1; > 6 s =2) - Livelli fibrinogeno (>1 g/l = 0, < 1 g/l =1) SCORE >5 compatibile (ripetere ogni giorno) < 5 suggestivo NON CID (ripetere dopo 1 -2 gg) Score pari a 3 CID esclusa

Emolisi microangiopatica + trombocitopenia Endocardite anamnesi, clinica, ecocardio negativi Vasculite post farmaci anamnesi, clinica negative Vasculite autoimmune (LES, sclerodermia) ANA, anti DNA negativi, clinica incompatibile Infezioni virali markers negativi per CMV, HSV, EBV Possibili… 1) Sindrome uremico-emolitica (SEU) 2) Porpora trombotica trombocitopenica (PTT)

Esclusa SEU tipica per: - Ricerca citofluorimetrica tossina acida SHIGA- like di E. Coli: negativa - Funzionalità renale nella norma - Storia di diarrea NON sanguinolenta Possibili forme atipiche (5 -10% casi), ma…. Nel sospetto di PTT - Attività ADAMTS 13 < 3% (v. n. 46 - 120%) - v. WF: Ag 250% (v. n. 60 -150) - Multimeri v. WF in circolo aumentati - Anticorpi contro ADAMTS 13 positivi

Porpora Trombotica Trombocitopenica (PTT) - Microangiopatia trombotica caratterizzata da aggregazione piastrinica conseguente ischemia - Incidenza 3. 7 casi per milione - F: M = 2: 3 principalmente nella terza-quarta decade - Manifestazioni cliniche molteplici PENTADE SINTOMATOLOGIA 1) trombocitopenia 2) anemia emolitica microangiopatica 3) febbre 4) disfunzione renale (88 % dei casi) 5) disturbi neurologici (92% dei casi)

DIAGNOSI Anemia emolitica microangiopatica + trombocitopenia con o senza sintomi renali, neurologici o sistemici, in assenza di altre cause di microangiopatia. Diagnosi supportata da: - Attività ADAMTS 13 ridotta - Aumentati livelli di v. WF: Ag - Presenza di Multimeri v. WF - Anticorpi contro ADAMTS 13 (solo nelle forme secondarie) DIAGNOSI DI PTT!

Mortalità in assenza di terapia 90% Non attendere indagini di laboratorio per iniziare terapia!!!

Eterogeneità clinica Tipologie PTT - Forme croniche ereditarie “relapsing” (mutazioni ADAMTS 13). Eredità AR. Prima manifestazione porpora neonatale - Forme acute mediate da Ig. G neutralizzante ADAMTS 13, scatenate da diversi triggers

Fisiopatologia - Metalloproteinasi ADAMTS 13 cliva UL-VWF impedendo aggregazione piastrinica massiva - UL-VWF sintetizzati da cellule epiteliali più efficaci nel legare GPIb/IX/V e GPIIb/IIIa su piastrine favorendone l’aggregazione - Un difetto di ADAMTS 13, pertanto, determina formazione aggregati piastrinici mediato da multimeri di v. WF (UL-VWF) conseguente piastrinopenia - La formazione di aggregati piastrinici mediati da multimeri di v. WF (UL-VWF) determina danno meccanico degli eritrociti conseguente formazione di schistociti allo striscio periferico (>10%) che vengono rimossi dal sistema reticolo endoteliale

TERAPIA - Plasma exchange terapia di prima scelta rimozione ULVWF e anticorpi vs ADAMTS 13 + ripristino ADAMTS 13 - Risposta variabile dal 60 all’ 80% dei pz - > Efficacia vs plasma (ripristino ADAMTS 13 ma NON rimozione UL-VWF e anticorpi inibenti ADAMTS 13) - Solo in pazienti con deficit ADAMTS 13 secondario associare terapia immunosoppressiva con steroidi - In pazienti non responders rituximab Conta piastrinica parametro più precoce per monitorare risposta alla terapia

E Giuseppe…? - Posizionamento CVC femorale per inizio plasma exchange (1 seduta/die) - Continua terapia con Metilprednisolone: 100 mg/die - Dopo 3 sedute di plasma exchange: Hb 9. 7 g/dl (valore partenza 8. 5 g/dl), PLT 104. 00/mm 3 (valore partenza 11. 000/mm 3), LDH 1450 IU/L (valore di partenza 2800) - Continua plasma exchange

PFC PEX PEX PEX PFC PEX PEX RITUXIMAB

g/dl PFC PEX PEX PEX PFC PEX PEX PEX RITUXIMAB

PEX PEX PEX PFC PEX PEX IU/L RITUXIMAB PFC PEX PFC

Ma dopo 5 settimane di terapia: caduta dei livelli di PLT (70. 000/ mmc) e Hb (9. 5 g/dl) aggiunge alla terapia rituximab: 375 mg/m 2/settimana per 4 settimane

Già dopo 2 dosi di Rituximab: - Normalizzazione livelli di PLT (200. 000/mmc) e Hb (12. 4 g/dl) - Incremento attività ADAMTS 13 (34%, v. n. 45 -138%) - Sospende plasma exchage e, progressivamente terapia steroidea (valori piastrinici nella norma!) - Depauperamento linfociti B (infusione IGIV ogni 4 settimane fino a ripristino dei linfociti B)

Giuseppe oggi… A 1 anno di follow-up -Valori ematologici nella norma: Hb 13. 9 g/dl, PLT 269. 000/mmc, LDH 450 U. I. (v. n. 230 -450) -Normalizzazione CD 20 : 9% sospende IGIV -Ultimi valori attività ADAMTS 13: 144% -Anticorpi anti ADAMTS 13: assenti!

Take Home Messages - Considerare PTT nella diagnosi differenziale della piastrinopenia associata ad anemia anche in età pediatrica - Importanza dello striscio periferico nella diagnosi differenziale di anemia e piastrinopenia (schistociti) - Iniziare terapia anche in caso di sospetto clinico in attesa del risultato degli esami laboratoristici più specifici - Necessario follow-up per possibili complicanze indotte dalla terapia (infezioni, ipogammaglobulinemia)